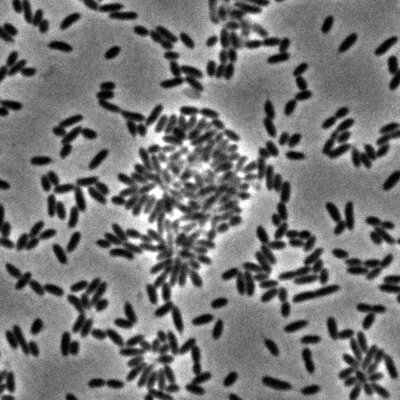
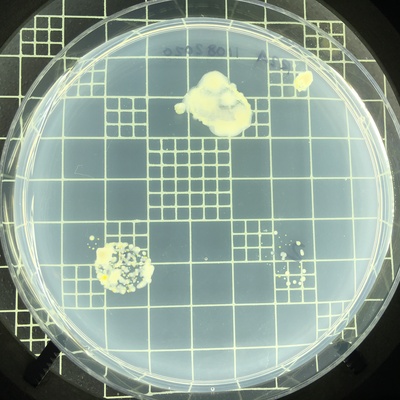
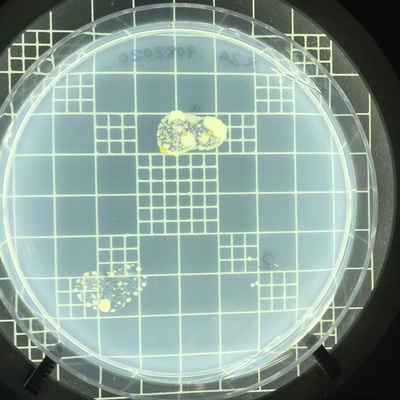
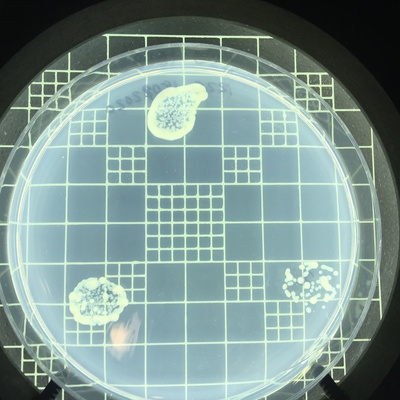
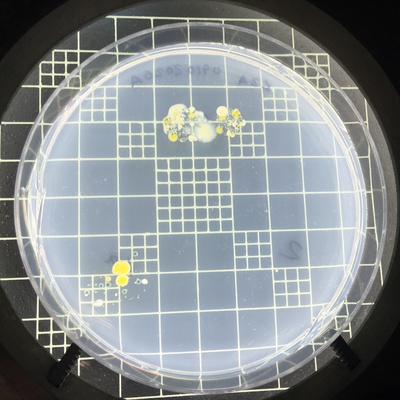

Recent photos
-

Lachine Canal at Pont Charlevoix, 19 August 2020 -
Lachine Canal at Pont Charlevoix, 9 October 2020 -

Lachine Canal at Pont Charlevoix, 9 October 2020 -

Lachine Canal at Pont Charlevoix, 9 October 2020 -
Lachine Canal at Pont Charlevoix, 11 August 2020 -
Lachine Canal at Pont Charlevoix, 13 August 2020 -
Lachine Canal at Pont Charlevoix, 19 August 2020 -
Lachine Canal at Pont Charlevoix, 18 September 2020 -
Lachine Canal at Pont Charlevoix, 9 October 2020 -
inconnu, 31 December 2021 -

inconnu, 10 October 2021 -

inconnu, 10 October 2021 -

inconnu, 10 October 2021 -

inconnu, 10 October 2021 -

inconnu, 9 October 2021 -

inconnu, 9 October 2021 -

Rivière Kedgwick - Ruisseau du village de kedgwick - Rue Jeanne d'Arc / 2ème avenue, 10 October 2021 -

Lachine Canal at Pont Charlevoix, 14 August 2020 -

Lachine Canal at Pont Charlevoix, 14 August 2020 -
Villa Maria School, 28 May 2021